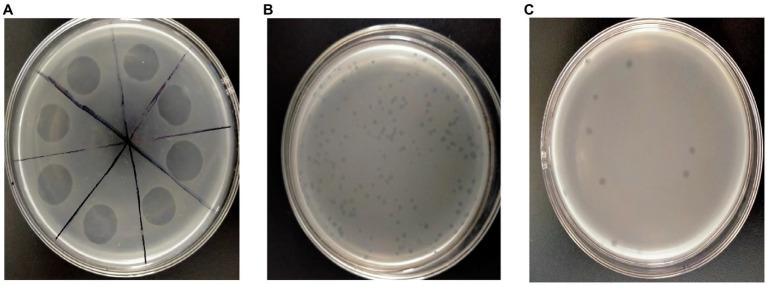
https://cdn.ncbi.nlm.nih.gov/pmc/blobs/daa6/10964948/1a31ef827d72/fmicb-15-1370332-g001.jpg

噬菌体LDT325的生物学特性及其对植物病原菌的潜在应用
Biological characteristics of the bacteriophage LDT325 and its potential application against the plant pathogen .
作者信息
Liu Li, Wang Bing, Huang Anqi, Zhang Hua, Li Yubao, Wang Lei
机构信息
College of Agriculture and Agricultural Engineering, Liaocheng University, Liaocheng, China.
出版信息
Front Microbiol. 2024 Mar 12;15:1370332. doi: 10.3389/fmicb.2024.1370332. eCollection 2024.
Bud blight disease caused by is a major bacterial disease of tea plants in China. Concerns regarding the emergence of bacterial resistance to conventional copper controls have indicated the need to devise new methods of disease biocontrol. Phage-based biocontrol may be a sustainable approach to combat bacterial pathogens. In this study, a phage was isolated from soil samples. Based on morphological characteristics, bacteriophage vB_PsS_LDT325 belongs to the Siphoviridae family; it has an icosahedral head with a diameter of 53 ± 1 nm and nonretractable tails measuring 110 ± 1 nm. The latent period and burst size of the phage were 10 min and 17 plaque-forming units (PFU)/cell, respectively. Furthermore, an analysis of the biological traits showed that the optimal multiplicity of infection (MOI) of the phage was 0.01. When the temperature exceeded 60°C, the phage titer began to decrease. The phage exhibited tolerance to a wide range of pH (3-11) and maintained relatively stable pH tolerance. It showed a high tolerance to chloroform, but was sensitive to ultraviolet (UV) light. The effects of phage LDT325 in treating infections were evaluated using a tea plant. Plants were inoculated with 2 × 10 colony-forming units (CFU)/mL using the needle-prick method and air-dried. Subsequently, plants were inoculated with 2 × 10 PFU/mL LDT325 phage. Compared with control plants, the bacterial count was reduced by 1 log10/0.5 g after 4 days in potted tea plants inoculated with the phage. These results underscore the phage as a potential antibacterial agent for controlling .
由[病原体名称缺失]引起的芽枯病是中国茶树的一种主要细菌性病害。由于担心细菌对传统铜制剂产生抗性,因此需要设计新的病害生物防治方法。基于噬菌体的生物防治可能是对抗细菌病原体的一种可持续方法。在本研究中,从土壤样本中分离出一种噬菌体。根据形态特征,噬菌体vB_PsS_LDT325属于长尾噬菌体科;它有一个直径为53±1 nm的二十面体头部和长度为110±1 nm的不可收缩尾部。该噬菌体的潜伏期和裂解量分别为10分钟和17个噬菌斑形成单位(PFU)/细胞。此外,生物学特性分析表明,该噬菌体的最佳感染复数(MOI)为0.01。当温度超过60°C时,噬菌体效价开始下降。该噬菌体对广泛的pH范围(3-11)具有耐受性,并保持相对稳定的pH耐受性。它对氯仿具有高耐受性,但对紫外线(UV)敏感。使用茶树评估了噬菌体LDT325在治疗[病害名称缺失]感染方面的效果。采用针刺法将植物接种2×10个菌落形成单位(CFU)/mL[病原体名称缺失],然后风干。随后,给植物接种2×10 PFU/mL的LDT325噬菌体。与对照植物相比,接种噬菌体的盆栽茶树在4天后细菌数量减少了1 log10/0.5 g。这些结果强调了该噬菌体作为控制[病害名称缺失]的潜在抗菌剂的作用。